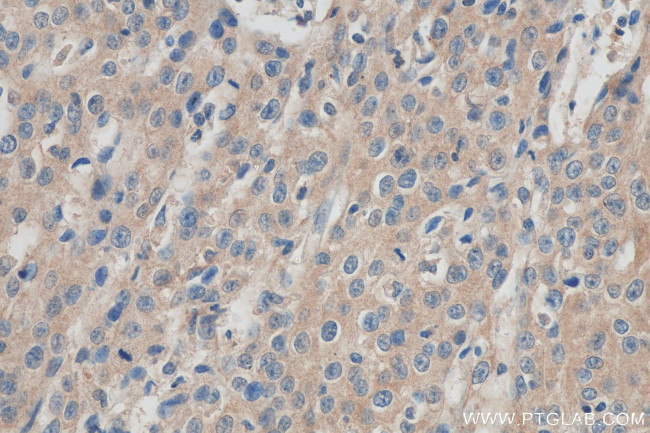
TMPRSS3 Antibody in Immunohistochemistry (Paraffin) (IHC (P))

Search
Proteintech
TMPRSS3 Polyclonal Antibody
{{$productOrderCtrl.translations['antibody.pdp.commerceCard.promotion.promotions']}}
{{$productOrderCtrl.translations['antibody.pdp.commerceCard.promotion.viewpromo']}}
{{$productOrderCtrl.translations['antibody.pdp.commerceCard.promotion.promocode']}}: {{promo.promoCode}} {{promo.promoTitle}} {{promo.promoDescription}}. {{$productOrderCtrl.translations['antibody.pdp.commerceCard.promotion.learnmore']}}
产品信息
17953-1-AP
种属反应
宿主/亚型
分类
类型
抗原
偶联物
形式
浓度
规格
纯化类型
保存液
内含物
保存条件
运输条件
产品详细信息
Immunogen sequence: LYLPKSWTI QVGLVSLLDN PAPSHLVEKI VYHSKYKPKR LGNDIALMKL AGPLTFNEMI QPVCLPNSEE NFPDGKVCWT SGWGATEDGG DASPVLNHAA VPLISNKICN HRDVYGGIIS PSMLCAGYLT GGVDSCQGDS GGPLVCQERR LWKLVGATSF GIGCAEVNKP GVYTRVTSFL DWIHEQMERD LKT (262-453 aa encoded by BC074846)
靶标信息
This gene encodes a protein that belongs to the serine protease family. The encoded protein contains a serine protease domain, a transmembrane domain, a LDL receptor-like domain, and a scavenger receptor cysteine-rich domain. Serine proteases are known to be involved in a variety of biological processes, whose malfunction often leads to human diseases and disorders. This gene was identified by its association with both congenital and childhood onset autosomal recessive deafness. This gene is expressed in fetal cochlea and many other tissues, and is thought to be involved in the development and maintenance of the inner ear or the contents of the perilymph and endolymph. This gene was also identified as a tumor associated gene that is overexpressed in ovarian tumors. Alternatively spliced transcript variants have been described.
仅用于科研。不用于诊断过程。未经明确授权不得转售。
生物信息学
蛋白别名: Serine protease TADG-12; Transmembrane protease serine 3; transmembrane protease, serine 3; transmembrane proteinase serine 3; Tumor-associated differentially-expressed gene 12 protein; unnamed protein product
基因别名: DFNB10; DFNB8; ECHOS1; TADG12; TMPRSS3; UNQ323/PRO382
UniProt ID: (Human) P57727, (Mouse) Q8K1T0
Entrez Gene ID: (Human) 64699, (Mouse) 140765, (Rat) 309665